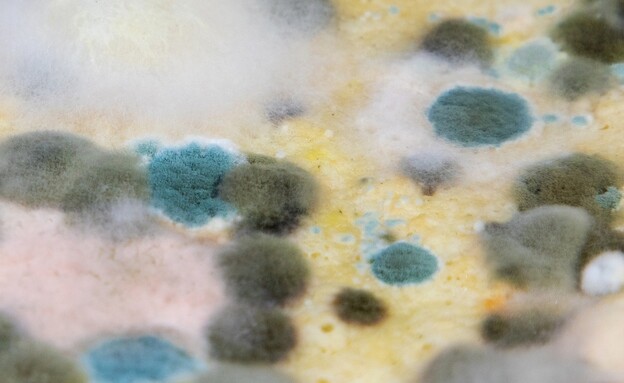

אדריכלות>


פחות מ־25 מ"ר: הדירה הסודית בקניון המפורסם
דירה זעירה בתוך קניון היסטורי: כך נראה הנכס

יש לכם מדרגות בבית? אתם חייבים לראות את זה
כי אפשר לנצל את החלל הזה כמו שצריך
אבזור>


מצאנו כורסה מגניבה ונוחה למרפסת במחיר הוגן

לא הספקתם להתארגן על מתנה לפסח? 31 מארזי חג
קבלו רעיונות מפנקים למארחים, למשפחה ולעצמכם
חדרים>


5 ילדים ובלוג מצליח: הבית המשפחתי של חן קורן
טפטים שמחים, הרבה אישיות וחדרי ילדים הורסים

כמה כישרון: הפכה מרפסת שירות לחדר תינוק מושל
גינות ומרפסות>


הפעולה שכדאי לעשות עם הצמח היפה באביב
לון זמן קצר שבו כמה פעולות פשוטות ישפיעו

הבצל התחיל לנבוט? זה מה שכדאי לעשות
רבים סבורים שבצל שמתחיל לנבוט מתקלקל
עשה זאת בעצמך>


מחברים את המכשיר הזה למפצל? אל

מצאנו דרך גאונית לנקות מתחת למכונת כביסה
ועוד טיפים מעולים לארגון הבית